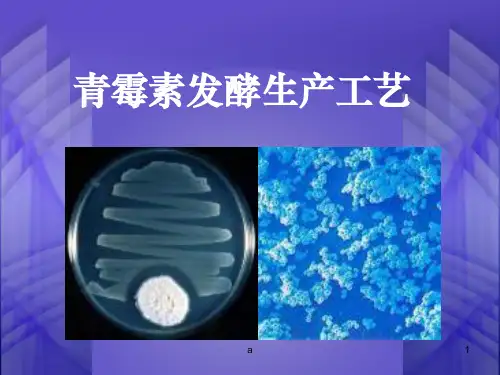

盘尼西林合成方法综述
- 格式:docx
- 大小:305.90 KB
- 文档页数:7

6-氨基青霉烷酸的合成6-氨基青霉烷酸(6-Aminopenicillanic acid,简称6-APA)是一种重要的有机合成中间体,也是许多半合成青霉素类抗生素的前体。
青霉素类抗生素广泛应用于临床上,对许多细菌感染具有高效杀菌作用。
而6-APA作为青霉素类抗生素的核心结构,其合成方法的研究对于提高抗生素的产量和质量具有重要意义。
我们可以从天然产物青霉素中提取6-APA。
青霉素是一种由青霉菌属(Penicillium)产生的抗生素,其分子结构中含有β-内酰胺环。
通过对青霉素的水解反应,可以将β-内酰胺环断开,得到6-APA。
这种方法简单直接,但产量较低,且难以控制反应条件,因此不适用于工业生产。
我们可以通过合成方法来制备6-APA。
合成方法主要分为两个步骤:首先是合成青霉素的侧链,然后在侧链上引入氨基基团。
青霉素的侧链通常是由丙氨酸和天冬氨酸等氨基酸组成的。
通过化学合成的方法,可以从这些氨基酸出发,经过一系列的反应,合成出青霉素的侧链。
例如,可以通过酰氯化反应将丙氨酸和天冬氨酸转化为酰氯衍生物,然后通过缩合反应将酰氯衍生物与其他化合物连接起来,最终得到青霉素的侧链。
接下来,在合成的青霉素侧链上引入氨基基团。
最常用的方法是通过酰胺化反应,将侧链上的羧基与氨基反应,生成酰胺。
这个反应可以在碱性或中性条件下进行,产率较高。
另外,还可以通过还原反应将侧链上的羧基还原为醛基,然后与氨基反应生成酰胺。
合成得到的6-APA可以进一步用于合成各种青霉素类抗生素。
通过在6-APA的侧链上引入不同的官能团,可以合成出具有不同抗菌活性和药代动力学特性的青霉素类化合物。
例如,通过在6-APA的侧链上引入苄基和氨基甲酰基,可以合成出青霉素G;通过在6-APA 的侧链上引入丁基和氨基甲酰基,可以合成出青霉素V。
青霉素类抗生素广泛应用于医药领域,对多种细菌感染具有高效杀菌作用。
其中,青霉素G是最早发现的青霉素类抗生素之一,被广泛应用于临床。

青霉素G的提取工艺的研究学院:环境与化学工程学院班级: 09级生物化工姓名:李建章学号: 9指导老师:张晓宇青霉素G的提取工艺的研究1927年,人们发现了青霉素(penicillin),这是应用于临床的第一种抗生素。
青霉素属于天然β-内酰胺类抗生素,是目前生产量最大的抗生素。
青霉素及半合成青霉素是临床应用极为广泛的抗菌药物,由于其抗菌作用强、疗效高、毒性低等优点,目前仍广泛应用于临床,而且在治疗很多感染疾病中仍为首选药物。
青霉素还是裂解生产半合成抗生素中间体及头孢菌素类抗生素的重要中间体和原料。
由于在商业生产和治疗中的重要性,直至在被发现80多年后的今天,青霉素仍然是世界最重要的生化产品之一。
图1.1青霉素的化学结构式青霉素是能破坏细菌的细胞壁并在细菌细胞的繁殖期起杀菌作用的一类抗生素。
青霉素分子中含有6个不对称碳原子,故具有旋光性。
不同的侧链R构成不同类型的青霉素,可分为G型、V型及0型等。
若R为苄基则为苄青霉素或叫青霉素G;若R为苯氧甲基,则为苯氧甲基青霉素或叫青霉素V。
天然青霉素(由发酵所得)有8种,以青霉素G疗效最好,应用最广。
青霉素G又称苄青霉素、盘尼西林,是一种天然青霉素,是青霉菌分泌的一种有机酸,pKa=2.75其化学结构式如图1.1所示,青霉素G分子中含有一仰.内酰胺环和一个游离羧基,前者鄙.内酰胺类抗生素多:有的特征,后者使其呈弱酸性。
青霉素作为一种有机弱酸,在水溶液中存在电离平衡,青霉素易被胃酸破坏,口服不易吸收,临床上以其钾盐或钠盐的形式采用肌肉注射或气雾吸收。
青霉素G钾(钠)主要是通过破坏细菌细胞壁达到杀菌作用,是治疗革兰氏阳性菌及部分阴性菌感染的首选药物。
青霉素的大规模生产采用的是生物发酵法,其分离提纯过程包括过滤、提取、共沸结晶等工序。
常见的发酵液中青霉素的提取方法有吸附法、沉淀法、溶媒萃取法、双水相萃取、反胶团萃取、超临界流体萃取和液膜法等。
但本设计是通过溶媒萃取工艺以及中空纤维更新液膜提取工艺进行介绍。

青霉素的提取工艺青霉素(Benzylpenicillin / Penicillin)又被称为青霉素G、peillin G、盘尼西林、配尼西林、青霉素钠、苄青霉素钠、青霉素钾、苄青霉素钾。
青霉素是抗菌素的一种,是指从青霉菌培养液中提制的分子中含有青霉烷、能破坏细菌的细胞壁并在细菌细胞的繁殖期起杀菌作用的一类抗生素。
青霉素类抗生素是β—内酰胺类中一大类抗生素的总称。
(图1。
青霉素分子式)化学特性青霉素又称盐酸巴氨西林。
其化学名为1—乙氧甲酰乙氧6-〔D(-)—2-氨基-2-乙酰氨基〕青霉烷酸盐酸盐.是一种有机酸,性质稳定,难溶于水.可与金属离子或有机碱结合成盐,临床常用的有钠盐、钾盐。
青霉素盐如青霉素钾或钠盐为白色结晶性粉末,无臭或微有特异性臭,有引湿性。
干燥品性质稳定,可在室温保存数年而不失效,且耐热。
遇酸、碱、重金属离子及氧化剂等即迅速失效。
极易溶于水,微溶于乙醇,不溶于脂肪油或液状石蜡.其水溶液极不稳定,在室温中效价很快降低10%,水溶液pH为5。
5~7。
5。
青霉素价格较为便宜,因而也证明了生产并提取青霉素是有着较为成熟的工业方法的.(图2青霉素的售价)青霉素的提纯青霉素提纯工艺流程简图:(图3)因为青霉素水溶液不稳定,故发酵液预处理、提取和精制过程要条件温和、快速,防止降解。
在提炼过程中要遵循下面三个原则:错误!时间短错误!温度低错误!pH适中1.预处理发酵结束后,目标产物存在于发酵液中,浓度较低,只有10-30kg/m3,并且含有大量杂质,如高价无机离子(Ca,Mg,Fe离子),菌丝,未用完的培养基,易污染杂菌,产生菌的代谢产物,蛋白质等。
因此必须对其进行的预处理,其目的在于浓缩目的产物,去除大部分杂质,利于后续的分离纯化过程,是进行分离纯化的第一个工序。
2.过滤发酵液在萃取之前需预处理,可在发酵液加少量絮凝剂沉淀蛋白(比如明矾),或者调解发酵液pH至蛋白质的等电点以沉淀蛋白,然后经真空转鼓过滤(以负压作过滤推动力)或板框过滤(浮液用泵送入滤机的每个密闭的滤室,在工作压力的作用下,滤液透过滤膜或其它滤材,经出液口排出,滤渣则留在框内形成滤饼,从而达到固液分离目的),除掉菌丝体及部分蛋白.青霉素在常温下易降解,因而发酵液及滤液应冷至10 ℃以下,过滤收率一般90%左右。

盘尼西林类药物分子合成技术研究盘尼西林是一类被广泛应用于临床的抗生素,其具有广谱抗菌活性,对许多细菌感染具有较高的疗效。
然而,细菌对抗生素的耐药性逐渐增强,导致了临床应用的效果下降。
因此,研究盘尼西林类药物的分子合成技术,对于发展新型抗菌药物和克服细菌耐药性具有重要意义。
盘尼西林类药物的分子结构由β-内酰胺环(β-lactam ring)和苯丙基侧链组成。
在药物分子合成技术中,关键的步骤包括β-内酰胺环的形成、苯丙基侧链的引入以及不同官能团的保护和去保护。
β-内酰胺环的形成是合成盘尼西林类药物的关键步骤之一。
目前常用的合成方法包括羧酸与氨基化合物的反应、氧化焦磷酸与活性亲核试剂的反应以及氨基醇与醛的反应。
这些方法都可以有效地构建β-内酰胺环,但每种方法具有不同的条件和适用范围,需要根据具体的合成需求进行选择。
苯丙基侧链的引入是盘尼西林类药物合成过程中的另一个重要步骤。
常用的方法是通过肼或苄胺与丁二酸二酯发生缩合反应,生成不同的苯丙基二酯,然后再与β-内酰胺环进行酰基化或酰胺化反应。
这些反应不仅能引入苯丙基侧链,还可以通过调整反应条件和底物结构,控制产物的立体化学和官能团的引入位置。
在盘尼西林类药物分子合成过程中,还需要对不同官能团进行保护和去保护。
常用的保护基包括酯基、醚基和二甲基苯基基(DMP)等。
这些保护基能在合成过程中保护特定官能团的反应活性,避免其发生不受控制的反应。
而去保护步骤则是通过适当的试剂和条件,去除保护基,使被保护的官能团恢复反应活性。
保护和去保护的选择需根据具体的反应条件和合成策略进行优化,以确保产物的纯度和收率。
随着化学合成技术的不断进步,越来越多的分子合成方法被应用于盘尼西林类药物的制备。
例如,光化学合成技术在盘尼西林类药物的合成中得到了广泛的应用。
光化学合成利用可见光或紫外光激发底物分子,促使其发生特定的反应,实现对底物结构的改造。
这种方法具有高选择性、高效率和环境友好的特点,能够实现对目标分子的高效、可控合成。

论青霉素类抗生素的发酵生产工艺摘要:青霉素作为当下最普遍、效果较好的抗生素类药物,广泛被大家所接受。
我们就抗生素的整体概述,青霉素的生产工艺及其发酵过程中可能出现的问题的解决方法还有宏观的经济考虑向大家进行介绍。
让大家能更多一层地了解青霉素——这个为大家广泛所知而又知之胜少的抗生素。
关键词:抗生素,青霉素,发酵工艺。
一、抗生素的概述抗生素是某些细菌、放线菌、真菌等微生物的次级代谢产物,或用化学方法合成的相同化合物或结构类似物,在低浓度下对各种病原性微生物或肿瘤细胞有强力杀灭作用或有其他药理作用的药物。
名称演变:抗生素—抗菌素—抗生素。
作用它的作用大致有五点:抗细菌感染、治疗肿瘤、抗病原虫、免疫抑制剂、刺激植物生长。
来源生物合成(发酵)、化学合成(全合成和半合成)降低毒性、减少耐药性、改善生物利用度、扩大抗菌谱、提高治疗效果。
分类以其化学结构分类:1青霉素类2.头孢菌素类3.磷霉素类4.万古霉素类5.利福霉素类6.多粘菌素类7.氨基糖甙类8.四环素类9.大环內酯类10.氯胺苯醇类11.林可霉素类根据抗生素化学结构及作用机理可分为以下几类:1)β-内酰胺类:青霉素类和头孢菌素类的分子结构中含有β-内酰胺环。
近年来又有较大发展,如硫酶素类、单内酰环类,β-内酰酶抑制剂、甲氧青霉素类等。
2.)氨基糖甙类:包括链霉素、庆大霉素、卡那霉素、妥布霉素、丁胺卡那霉素、新霉素、核糖霉素、小诺霉素、阿斯霉素等。
3)四环素类:包括四环素、土霉素、金霉素及强力霉素等。
4)氯霉素类:包括氯霉素、甲砜霉素等。
5)大环内脂类:临床常用的有红霉素、白霉素、无味红霉素、乙酰螺旋霉素、麦迪霉素、交沙霉素等。
6)作用于G+细菌的其它抗生素:如林可霉素、氯林可霉素、万古霉素、杆菌肽等。
7)作用于G-菌的其它抗生素:如多粘菌素、磷霉素、卷霉素、环丝氨酸、利福平等。
8)抗真菌抗生素:如灰黄霉素。
9)抗肿瘤抗生素:如丝裂霉素、放线菌素D、博莱霉素、阿霉素等。

青霉素生产工艺青霉素(Penicillin)是一种广泛应用于抗生素领域的药物,用于治疗多种细菌感染。
青霉素的生产工艺是一个复杂的过程,需要经过多个步骤才能得到高质量的药物产品。
下面将介绍一种常见的青霉素生产工艺。
首先,在青霉菌(Penicillium chrysogenum)的培养基中,加入碳源(如葡萄糖)、氮源(如酵母浸没物)和一些微量元素,如氯化钾和硫酸镁。
将培养基放入发酵罐中,使其产生青霉素。
青霉菌培养过程通常分为两个阶段:生长阶段和产青霉素阶段。
在生长阶段,培养基中的碳源和氮源为青霉菌提供了生长所需的营养物质。
同时,培养罐中的温度、湿度和通氧量等条件都要合适,以保证菌体的正常生长。
在合适的条件下,青霉菌会快速繁殖并形成菌群。
当菌群达到一定密度时,进入产青霉素阶段。
此时,青霉菌开始产生青霉素。
在产青霉素的过程中,青霉菌分泌的酶能够将培养基中的碳源转化为青霉素,同时酶还能代谢一部分底物,产生其他有机物。
接下来,菌群的培养液经过离心机离心分离,将菌体和培养液分离开来。
分离后的菌体可以进一步用于青霉菌发酵罐中的细菌接种,以继续产生青霉素。
分离得到的培养液中含有一定量的青霉素和其他有机物。
为了提取纯净的青霉素,需要对培养液进行一系列的处理。
首先,通过加入酸或碱,使得青霉素以盐酸或乳酸钠的形式沉淀出来。
沉淀物再经过过滤、洗涤和干燥等步骤,得到青霉素的粗品。
粗品青霉素还需要进一步经过结晶、过滤和干燥等处理,以提高纯度。
通过控制温度和浓度等因素,在合适的条件下,青霉素在溶液中结晶形成晶体。
晶体经过过滤和干燥后,得到纯净的青霉素产品。
最后,在生产工艺的最后阶段,青霉素产品需要经过包装、封装和标签贴附等处理,以便于存放和使用。
同时,还需要对产品进行质量检测,确保符合国家标准和规定。
通过上述生产工艺,可以获得高质量的青霉素产品。
青霉素的生产工艺是一个非常复杂的过程,需要严格控制各个步骤的条件和参数,以确保产出的产品纯净、安全、有效。

青霉素类抗生素的生物制药工艺研究专业班级生物工程学号 101454218姓名汪芳俊摘要:抗生素指由细菌、霉菌或其它微生物在生活过程中所产生的具有抗病原体或其它活性的一类物质。
青霉素的使用使人类战胜了因为各类感染所带来的痛苦,由于抗生素的优良抗菌抗病毒做用,抗生素的使用一直被密切研究,新型抗生素的研发和使用更是意义重大,并且有不可估量的经济效益。
通过对抗生素生产工艺的不断学习和研究,本文引以青霉素的生产工艺为例,从而对揭示各类抗生素的工业生产工艺,为抗生素的生产和研究提供指导。
关键词:抗生素;青霉素;生产工艺;提炼;abstract:, the discovery and use of antibiotics to human health are higher than ever before, because all mankind overcome the pain caused by infection, Since antibiotics do good antibacterial and antiviral use, antibiotic use has been closely studied the development and use of new antibiotics is of great significance, and have immeasurable economic benefits. The term antibiotic production process through the continuous study and research, the paper cited an example to penicillin production process, thus revealing all kinds of antibiotics in industrial production processes for antibiotic production and research guidance.key words :Antibiotics; penicillin; production process; extraction;1 前言抗生素是由微生物(包括细菌、真菌、放线菌属)或高等植物在生活过程中所产生的具有抗病原体或其它活性的一类次级代谢产物,能干扰其他生活细胞发育功能的化学物质。

盘尼西林合成方法综述盘尼西林合成方法综述姜昊(912103860236)化工学院摘要:青霉素(Penicillin,或音译盘尼西林)又被称为青霉素G、peillin G、盘尼西林、配尼西林、青霉素钠、苄青霉素钠、青霉素钾、苄青霉素钾。
青霉素是抗菌素的一种,是指分子中含有青霉烷、能破坏细菌的细胞壁并在细菌细胞的繁殖期起杀菌作用的一类抗生素,是由青霉菌中提炼出的抗生素。
在医药史上它与阿司匹林、安定并称为三大经典药物。
鉴于它在医药史上的重要性,本文就此介绍一些比较成熟,有效的合成方法。
关键词:青霉素合成方法青霉素是抗菌素的一种,是从青霉菌培养液中提制的药物,是第一种能够治疗人类疾病的抗生素。
青霉素的出现开创了用抗生素治疗疾病的新纪元。
在二战时期拯救了数千万人的生命。
天然青霉素:青霉素这族抗生素包括着若干种结构密切相联系的物质,他们共同的结构经证明如右式:应优先地进行。
此种反应收率只有百分之十,但对于合成天然青霉素已经比较高了。
半合成青霉素:半合成青霉素由于天然青霉素存在有抗菌谱窄、不耐胃酸口服无效及不耐酶易被水解等缺点,因此,通过改变天然青霉素G的侧链可获得耐酸、耐酶、广谱、抗铜绿假单胞菌及主要作用于G-菌等等一系列不同品种的半合成青霉素。
以6APA为中间体与多种化学合成有机酸进行酰化反应,可制得各种类型的半合成青霉素。
6APA是利用微生物产生的青霉素酰化酶裂解青霉素G或V而得到。
酶反应一般在40~50℃、pH8~10的条件下进行;近年来,酶固相化技术已应用于6APA生产,简化了裂解工艺过程。
6APA也可从青霉素G用化学法来裂解制得,但成本较高。
侧链的引入系将相应的有机酸先用氯化剂制成酰氯,然后根据酰氯的稳定性在水或有机溶剂中,以无机或有机碱为缩合剂,与6APA进行酰化反应。
缩合反应也可以在裂解液中直接进行而不需分离出6APA。
经过研究人员与科研人员的不断研究,关于半合成青霉素的合成有了很大的进展。
唐广安等[2]以D-天门冬氨酸和阿莫西林三水酸为原料,经过6步反应形成产物。

青霉素(Benzylpenicillin / Penicillin)又被称为青霉素G、peillin G、盘尼西林。
以下我要教大家的制作方法是从别的地方找的,由医学专家肯定过的方法。
还是比较行的。
1。
用米磨成的汁水 + 用山芋磨成的汁水作为培养基溶液(用个小碗)2。
将青霉移植进去(青霉就是找一个已经发霉的食物,上面的霉变物质刮下来就是),等1个星期。
培养中3。
拿一个小瓦罐(市场上有的,你买玻璃杯也可以)。
用塑料薄膜封住顶部(不要用盖子),在薄膜上剪个小孔,拿一个漏斗,在漏斗里放医用棉花,把培养过的培养液体从棉花上倒下去。
(有点像过滤)4。
在那个瓦罐里倒适量(培养液的3倍)的菜种油,搅拌吧~~ 5。
搅拌到最后会发现,罐子里的液体有3层(你看不见的,罐子不是透明的。
)6。
这时候,你要用小勺子慢慢地把上层的油和脂弄掉!(相信你还是分的清什么是油什么是水=0=),只留下底部的水7。
将碳粉(自己弄去)加入罐子,搅拌吧~~8。
碳会吸收青霉成分,罐子里的液体会吸干。
9。
取出碳,用蒸馏水(不要用其他水,否则就没用了,回污染的)洗涤碳,注意,一点点就好10。
用醋加水混合水洗涤碳11。
用海草汁水洗涤12。
重复步骤3的方法(再买一个瓦罐或者玻璃杯)过滤13。
将最后得到的液体分成每100CC一小杯。
等上几天(标号哦,1,2,3,。
)14。
最后一步很难哦!在你的嘘嘘中用棉花棒蘸上少许,分别滴在小杯子的中央15。
等待。
16。
过1 WEEK后,如果看到有一个中央没有青霉,只有周围一环有,就制作成了17。
用胶头滴管吸取环中的青霉,就是盘尼西林!!!!!!天然青霉素青霉素G生产可分为菌种发酵和提取精制两个步骤。
①菌种发酵:将产黄青霉菌接种到固体培养基上,在25℃下培养7~10天,即可得青霉菌孢子培养物。
用无菌水将孢子制成悬浮液接种到种子罐内已灭菌的培养基中,通入无菌空气、搅拌,在27℃下培养24~28h,然后将种子培养液接种到发酵罐已灭菌的含有苯乙酸前体的培养基中,通入无菌空气,搅拌,在27℃下培养7天。

盘尼西林合成方法综述姜昊(912103860236)化工学院摘要:青霉素(Penicillin,或音译盘尼西林)又被称为青霉素G、peillin G、盘尼西林、配尼西林、青霉素钠、苄青霉素钠、青霉素钾、苄青霉素钾。
青霉素是抗菌素的一种,是指分子中含有青霉烷、能破坏细菌的细胞壁并在细菌细胞的繁殖期起杀菌作用的一类抗生素,是由青霉菌中提炼出的抗生素。
在医药史上它与阿司匹林、安定并称为三大经典药物。
鉴于它在医药史上的重要性,本文就此介绍一些比较成熟,有效的合成方法。
关键词:青霉素合成方法青霉素是抗菌素的一种,是从青霉菌培养液中提制的药物,是第一种能够治疗人类疾病的抗生素。
青霉素的出现开创了用抗生素治疗疾病的新纪元。
在二战时期拯救了数千万人的生命。
天然青霉素:青霉素这族抗生素包括着若干种结构密切相联系的物质,他们共同的结构经证明如右式:它们的差别只在于R基的不同。
今天我们所知道的由霉菌合成的青霉素而其结构式已肯定者共有六种(见下表)在这些青霉素中,青霉素a和b是最早发现的。
多年以来,只有苯甲基青霉素是唯一广泛使用的青霉素,因此关于这个青霉素的化学也是研究得最广泛最深入的。
早期,青霉素的合成是十分困难的,一直通过生物合成的方法来进行。
[1]美国著名的化学家席恩对于青霉素合成进行了很多研究以后,1957年3月成功了天然青霉素之一种—青霉素v,结构式如下:席恩青霉素V合成法的特点在于:应用了非常温和的条件,同时使形成四环的反应但可能蛟其他可能进行的反应优先地进行。
此种反应收率只有百分之十,但对于合成天然青霉素已经比较高了。
半合成青霉素:半合成青霉素由于天然青霉素存在有抗菌谱窄、不耐胃酸口服无效及不耐酶易被水解等缺点,因此,通过改变天然青霉素G的侧链可获得耐酸、耐酶、广谱、抗铜绿假单胞菌及主要作用于G-菌等等一系列不同品种的半合成青霉素。
以6APA为中间体与多种化学合成有机酸进行酰化反应,可制得各种类型的半合成青霉素。
抗生素的合成与优化抗生素是一类专门用于抑制或杀灭细菌的药物,它在医疗领域中起着重要的作用。
本文将探讨抗生素的合成与优化的相关内容。
一、抗生素的合成方法1. 自然来源抗生素最初是从微生物中提取得到的,比如青霉素就是从青霉菌中提取得到的。
这种方法的优点是原料简单、产量较大,但提取过程较为复杂,纯度较低。
2. 化学合成化学合成是人工合成抗生素的一种常见方法,通过有机合成化学反应来合成抗生素分子。
这种方法优点是纯度高、产量可控,但合成过程中存在复杂的合成路线和条件,且成本较高。
3. 半合成半合成是综合利用自然来源和化学合成的方法。
一般是通过合成方法将天然的抗生素结构进行化学修饰,以改善其性质或增强活性。
这种方法具有较高的特异性和活性,能够在一定程度上减少副作用。
二、抗生素的合成优化策略抗生素的合成优化旨在改善其治疗效果和减少副作用,以下列举几种常见的优化策略。
1. 结构修饰通过对抗生素分子结构进行修改和修饰,可以改变药物的特性和性质。
比如,可以通过基团替换、尺寸调整等方式来增加药物的稳定性、活性和选择性。
2. 组合疗法抗生素的组合疗法是将两种或多种不同的抗生素联合使用,以增强疗效和减少耐药性。
通过选择具有互补的药物和作用机制,可以提高治疗成功率。
3. 新型合成方法研发新型合成方法是改善抗生素合成效率和降低成本的重要途径。
比如,引入新的催化剂、改变反应条件等,可以提高合成反应的速度和产率。
4. 靶向设计靶向设计是针对细菌特定靶点的抗生素设计策略。
通过研究细菌的生理过程和药物作用机制,可以针对性地设计抗生素,提高药物的作用效果和选择性。
5. 研发新型抗生素随着细菌对传统抗生素的耐药性增强,研发新型抗生素成为当前的重要任务之一。
通过发现新的天然来源、设计合成新结构或探索新的治疗靶点,可以开发出具有更高活性和更低毒性的抗生素。
三、抗生素合成与优化的挑战抗生素合成和优化面临着一些挑战,以下列举几个常见的问题。
1. 耐药性细菌的耐药性是抗生素合成和优化的主要挑战之一。
10.盘尼西林V10.1 引言盘尼西林属于疏水性的β-内酰胺一族,也是最重要的抗生素之一。
它们产生于盘尼西林产黄青霉。
2001年,劳氏【10.1】分析了全球盘尼西林的产量为65000公吨。
不仅是盘尼西林G,盘尼西林V(苯氧甲基青霉素)也是商业里最重要的盘尼西林。
它主要被传导至6-氨基青霉烷酸(6-APA)中,用来生成阿莫西林和氨比西林【10.2】。
而且,它被直接用作抗生素,位列全美处方药前100【10.3】。
在这个案例分析里,我们重点利用蒙特卡洛模拟(MCS)来分析参数不确定性对整体生产过程的影响。
首先,我们开发了一个基础模型,之后会在MCS中用到。
这个基本模型和不确定性分析在Biwer及其他地方有细节描述。
【10.4】10.2 建立基本模型10.2.1 发酵模型盘尼西林V是新陈代谢中低产率的次级产物,它的合成过程在文献中有扩展性描述【比如,10.5,10.6】。
盘尼西林合成始于三种活化氨基酸,涉及几种酶和异盘尼西林N作为培养基【10.7】。
一个典型的培养基由葡萄糖、玉米浆、矿物质盐组成,苯氧基乙酸作为前体【10.8-10.10】。
盘尼西林产黄青霉难合成盘尼西林的苯酚侧链。
因此,向培养介质中持续加入苯氧基乙酸作为前体。
在这个案例里,我们用一个简化的生物反应模型来描述最终产物和生物量的聚集在单元生产和维修率,以及特定的产品形成速率和生产率之间的相关性。
从文献和生产过程中摘录的模型参数的值见表10.1。
其中设想了两个生物反应阶段(生长和生产)。
第一个(主要)阶段持续50h,在这段时间里主要是在批次培养中生产生物大分子。
生物大分子的形成减缓后,盘尼西林V在第二过程中生产超过160h。
第二阶段中持续供给葡萄糖。
10.2.2 生产模型生产过程模型基于可获得的文献【10.1,10.9-10.11】。
我们假设一套有11个发酵罐的设备,每个发酵罐容积100m^3, 从而优化了下游设备的使用。
最终产品是盘尼西林V的钠盐。
盘尼西林是什么文章目录*一、盘尼西林是什么*二、盘尼西林的不良反应有哪些*三、盘尼西林发生过敏反应的急救措施盘尼西林是什么1、盘尼西林是什么盘尼西林一般指青霉素,青霉素,霉素是抗菌素的一种,是指分子中含有青霉烷、能破坏细菌的细胞壁并在细菌细胞的繁殖期起杀菌作用的一类抗生素,是由青霉菌中提炼出的抗生素。
青霉素又被称为青霉素G、peillin G、盘尼西林、配尼西林、青霉素钠、苄青霉素钠、青霉素钾、苄青霉素钾。
青青霉素属于β-内酰胺类抗生素(β-lactams),β-内酰胺类抗生素包括青霉素、头孢菌素、碳青霉烯类、单环类、头霉素类等。
青霉素是很常用的抗菌药品。
但每次使用前必须做皮试,以防过敏。
2、盘尼西林的主要功能青霉素是一种高效、低毒、临床应用广泛的重要抗生素。
它的研制成功大大增强了人类抵抗细菌性感染的能力,带动了抗生素家族的诞生。
它的出现开创了用抗生素治疗疾病的新纪元。
通过数十年的完善,青霉素针剂和口服青霉素已能分别治疗肺炎、肺结核、脑膜炎、心内膜炎、白喉、炭疽等病。
继青霉素之后,链霉素、氯霉素、土霉素、四环素等抗生素不断产生,增强了人类治疗传染性疾病的能力。
但与此同时,部分病菌的抗药性也在逐渐增强。
3、盘尼西林合成方法的综述青霉素是抗菌素的一种,是从青霉菌培养液中提制的药物,是第一种能够治疗人类疾病的抗生素,青霉素的出现开创了用抗生素治疗疾病的新纪元。
在二战时期拯救了数千万人的生命,天然青霉素,青霉素这族抗生素包括着若干种结构密切相联系的物质,半合成青霉素,半合成青霉素由于天然青霉素存在有抗菌谱窄、不耐胃酸口服无效及不耐酶易被水解等缺点,因此,通过改变天然青霉素G的侧链可获得耐酸、耐酶、广谱、抗铜绿假单胞菌及主要作用于G-菌等等一系列不同品种的半合成青霉素。
盘尼西林的不良反应有哪些1、过敏反应:青霉素过敏反应较常见,包括荨麻疹等各类皮疹、白细胞减少、间质性肾炎、哮喘发作等和血清病型反应;过敏性休克偶见,一旦发生,必须就地抢救,予以保持气道畅通、吸氧及使用肾上腺素、糖皮质激素等治疗措施。
青霉素的生产项目三:青霉素的生产一、实验相关知识1、青霉素又被称为青霉素G、盘尼西林、配尼西林、青霉素钠、苄青霉素钠、青霉素钾、苄青霉素钾。
青霉素是抗菌素的一种,是指从青霉菌培养液中提制的分子中含有青霉烷、能破坏细菌的细胞壁并在细菌细胞的繁殖期起杀菌作用的一类抗生素,是第一种能够治疗人类疾病的抗生素。
青霉素类抗生素是β-内酰胺类中一大类抗生素的总称,由于β-内酰胺类作用于细菌的细胞壁,而人类只有细胞膜无细胞壁,故对人类的毒性较小,除能引起严重的过敏反应外,在一般用量下,其毒性不甚明显,但它不能耐受耐药菌株(如耐药金葡)所产生的酶,易被其破坏,且其抗菌谱较窄,主要对革兰氏阳性菌有效。
青霉素G有钾盐、钠盐之分,钾盐不仅不能直接静注,静脉滴注时,也要仔细计算钾离子量,以免注入人体形成高血钾而抑制心脏功能,造成死亡。
2、1929年英国学者弗莱明首先在抗生素中发现了青霉素,英国谢菲尔德大学病理学家弗洛里实现对青霉素的分离与纯化,并发现其对传染病的疗效,与英国生物化学家钱恩共获1945年诺贝尔奖。
青霉素分为天然的和半合成的,天然的青霉素是通过菌种发酵得到的。
3、理化性质:(1)溶解度:青霉素本身是一种游离酸,易溶于有机溶剂,但在水溶液中溶解度很小。
(2)吸湿性:青霉素的吸湿性与其内在质量有关;纯度越高,吸湿性越小,也就易于存放。
(3)稳定性:青霉素的水溶液是一种不稳定的化合物,而晶体状态比较稳定。
(4)酸碱性:青霉素的分子结构中有一个酸性基团(羧基),无碱性基团。
4、常见的化学反应:(1)青霉素的碱性水解(2)青霉素的酸性水解(完全水解和不完全水解)(3)青霉素的裂解5、青霉素应用的注意事项:①应用青霉素前应做皮试②青霉素不可与同类抗生素联用,不可与磺胺和四环素联合用药,不可与氨基糖苷类混合输液。
③宜短期使用,切忌长期大量给药,以免血药浓度持续升高,导致致敏物质的形成与堆积,造成过敏反应。
④通常静脉给药,宜慢不宜快,以每分钟不超过60滴的速度静脉滴注,以免血药浓度增高过快而增加分解过敏可能。
本技术涉及一种源于桔青霉的桔霉素类化合物penicitrinol O及其制备方法和应用。
该化合物具有抑制肿瘤细胞增殖作用,具有抗肿瘤活性。
其结构式为:。
通过发酵培养桔青霉 ( Penicillium citrinum ) IBPT-5,获取发酵物,然后从发酵物中分离纯化出该化合物。
经实验证实,该化合物对人宫颈癌细胞系hela具有较好的抗肿瘤活性。
可作为制备细胞增殖抑制药物或抗肿瘤药物用于抗肿瘤的研究。
权利要求书1.化合物。
2.如权利要求1所述化合物的制备方法,其特征在于:发酵培养桔青霉 (Penicillium citrinum) IBPT-5,获取发酵物,然后从发酵物中分离纯化出该化合物,所述桔青霉 (Penicillium citrinum) IBPT-5,已于2013年12月25日保藏在中国典型培养物保藏中心,地址: 武汉武汉大学,保藏编号是:CCTCC NO:M 2013713。
3.根据权利要求2所述的化合物的制备方法,其特征在于:所述制备方法的具体步骤如下:(1)发酵生产培养微生物的常规方法,取桔青霉(Penicillium citrinum)IBPT-5接种到PDA固体斜面培养基上在28℃培养箱中培养4天,然后接种到培养液中,28℃静止培养30天后,获得菌丝体和发酵液;所述培养液组成:每升水含甘露醇20.0g、酵母膏3.0 g、麦芽糖20.0 g、味精10.0 g、葡萄糖10.0 g、KH2PO4 0.5 g、MgSO4 0.3 g、NaCl 30.0 g;(2)浸膏的获得用纱布将菌丝体和发酵液分离,将发酵液用2倍体积的乙酸乙酯萃取两次,萃取液减压蒸馏至干,得到发酵液的乙酸乙酯浸膏;(3)化合物的分离精制该乙酸乙酯浸膏通过100-200目硅胶拌样后,以石油醚:二氯甲烷:甲醇为洗脱液用减压硅胶色谱柱梯度洗脱,收集二氯甲烷的洗脱物,以二氯甲烷:甲醇为洗脱液,进一步通过加压硅胶柱层析梯度洗脱,得到二氯甲烷:甲醇v/v=100:1的洗脱物,再通过半制备液相色谱1010型ODS-A,10×250 mm,5μm:分离流速为5 mL/min,流动相为70%乙腈含0.1% TFA,得到所述化合物,t R 8.3 min。
盘尼西林合成方法综述
姜昊(912103860236)化工学院
摘要:青霉素(Penicillin,或音译盘尼西林)又被称为青霉素G、peillin G、盘尼西林、配尼西林、青霉素钠、苄青霉素钠、青霉素钾、苄青霉素钾。
青霉素是抗菌素的一种,是指分子中含有青霉烷、能破坏细菌的细胞壁并在细菌细胞的繁殖期起杀菌作用的一类抗生素,是由青霉菌中提炼出的抗生素。
在医药史上它与阿司匹林、安定并称为三大经典药物。
鉴于它在医药史上的重要性,本文就此介绍一些比较成熟,有效的合成方法。
关键词:青霉素合成方法
青霉素是抗菌素的一种,是从青霉菌培养液中提制的药物,是第一种能够治疗人类疾病的抗生素。
青霉素的出现开创了用抗生素治疗疾病的新纪元。
在二战时期拯救了数千万人的生命。
天然青霉素:青霉素这族抗生素包括着若干种结构密切相联系的物质,他们共同
的结构经证明如右式:
它们的差别只在于R基的不同。
今天我们所知道的由霉菌合成的青霉素而其结构式已肯定者共有六种(见下表)
在这些青霉素中,青霉素a和b是最早发现的。
多年以来,只有苯甲基青霉素是唯一广泛使用的青霉素,因此关于这个青霉素的化学也是研究得最广泛最深入的。
早期,青霉素的合成是十分困难的,一直通过生物合成的方法来进行。
[1]美国著名的化学家席恩对于青霉素合成进行了很多研究以后,1957年3月成功了天然青霉素之一种—青霉素v,结构式如下:
席恩青霉素V合成法的特点在于:应用了非常温和的条件,同时使形成四环的反应但可能蛟其他可能进行的反应优先地进行。
此种反应收率只有百分之十,但对于合成天然青霉素已经比较高了。
半合成青霉素:半合成青霉素由于天然青霉素存在有抗菌谱窄、不耐胃酸口服无效及不耐酶易被水解等缺点,因此,通过改变天然青霉素G的侧链可获得耐酸、耐酶、广谱、抗铜绿假单胞菌及主要作用于G-菌等等一系列不同品种的半合成青霉素。
以6APA为中间体与多种化学合成有机酸进行酰化反应,可制得各种类型的半合成青霉素。
6APA是利用微生物产生的青霉素酰化酶裂解青霉素G或V而得到。
酶反应一般在40~50℃、pH8~10的条件下进行;近年来,酶固相化技术已应用于6APA生产,简化了裂解工艺过程。
6APA也可从青霉素G用化学法来裂解制得,但成本较高。
侧链的引入系将相应的有机酸先用氯化剂制成酰氯,然后根据酰氯的稳定性在水或有机溶剂中,以无机或有机碱为缩合剂,与6APA进行酰化反应。
缩合反应也可以在裂解液中直接进行而不需分离出6APA。
经过研究人员与科研人员的不断研究,关于半合成青霉素的合成有了很大的进展。
唐广安等[2]以D-天门冬氨酸和阿莫西林三水酸为原料,经过6步反应形成产物。
经过IR, 1 H-NMR和13 C-NMR分析,证明产物是阿扑西林。
本方法原料易得,反应条件温和,成本低,易于放大生产。
该反应的流程如下:
熊振平等[3]研究了以6APA为母核,d-苯甘氨酸甲酯盐酸盐或p-羟基-苯甘氨酸甲酯盐酸盐为侧链化合物,用酶缩合法制备苯苄青霉素(APC)羟苯苄青霉素(AMC),得到的收率相对较高。
夏莘强等[4]改进了左旋磺节青霉素的合成,苯乙酸的分拆系用L一赖氨酸为旋光分拆剂,甲醇为溶剂,使左右旋的磺苯乙酸赖氨酸盐分离,我们试验成功用水为溶剂进行分拆,用乙醇和水精致的方法,分拆所得右旋磺苯乙酸在碱性下煮沸即可消旋成消旋体,而用于再分拆,很简单地就解决了右旋体反复利用问题。
向红琳等[5]改进磺苄西林钠的合成工艺。
方法:以苯乙酸为原料,经磺化、手性拆分、酰氯化后,再与6-氨基青霉烷酸(6-APA)缩合、成盐制备磺苄西林钠。
对磺化反应和缩合反应进行了工艺改进。
反应总收率为46%,产品结构经IR、1HNMR等数据确证。
本工艺操作过程简单,
反应时间缩短,收率提高,适合工业化生产。
日本田边制药公司[6]开发出的世界第一支氨基酸型半合成青霉素aspc:
开发出了两种合成路线,一条路线系羟基苄青霉素与具有氨基保护剂的天冬酰胺缩合后再除去保护基,另一条路线为具有氨基保护基的天冬酰胺与对羟基苯甘氨酸缩合后再与6APA缩合,然后再除去保护基。
孙万儒等[7]深入探究了酰化酶对于半合成青霉素合成的影响,通过实验确定了ph,底物,酶用量,反应温度反应时间等对于反应的影响,该方法有反应条件温和,操作简便易于控制,基本无污染问题等优点。
从目前来看对某些产物的合成产率也已达到一定水平,利用酶的特异性,不仅可以从6一APA而且可以从青霉素G合成某一半合成青霉素。
由于酶的多功能性,某一酶既可以用于生产6一APA和7一ADCA,又可以用于合成青霉素和头抱菌素。
王华[8]采用微波辐射法研究了对青霉素G酰化酶的固定方法,青霉素G酰化酶具有巨大的工业应用价值,对青霉素的合成具有重大的意义。
陈凤英[9]以2-咪唑烷酮为起始原料,经甲磺酰化、酰化等四步反应,合成了酰脲类青霉素美洛西林钠。
在合成过程中用氯甲酸三氯甲酯替代光气对其重要中间体1-氯甲酰基-3-甲磺酰基-2-咪唑烷酮的合成工艺进行了改进,不仅避免了使用光气,而且收率也从文献值70%
提高到75%。
湖南制药厂实验室新青霉素合成组[10]研究制备氟氯青霉素钠
它是
继临床上已应用的苯甲异嚷哩青霉素钠、氯青霉素钠及双氯青霉素钠后的又一个新的耐
青霉素酶的异嗯哇类青霉素,与双氯青霉素钠同样的适用于某些对青霉素G具有耐药性或经一般抗菌素治疗无效的葡萄球菌感染。
氟氯青霉素钠的优点是口服后血中游离的青霉素浓度
要比双氯青霉素钠高一倍。
合成路线如下:
纵观这些反应和研究,都是为了更好更绿色的实现半合成青霉素的合成,但各自都有各自的局限性,在不久的将来,我相信更好更绿色高效的反应会被人们发现。
参考文献
[1]戴乾圜《化学通报》, 1957(10)
[2]唐广安,许激扬,邹巧根《中国新药杂志》, 2009(10):937-939
[3]顾康福,许文思,熊振平《中国医药工业杂志》, 1983(3)
[4]夏莘强,王清福,潘翠娥,吴凤桃,黄大钰《中国抗生素杂志》, 1981(1)
[5]向红琳,谭转云,杨小红《中国药科大学学报》, 2007, 38(6):496-498
[6]许铁男《国外医药:抗生素分册》, 1991(3):192-197
[7]孙万儒,张启先《国外药学:抗生素分册》, 1980(1)
[8]王华,王安明,周成,祝社民,宗璟《化学学报》, 2008, 66(2):271-275
[9]陈凤英《高校化学工程学报》, 2003, 17(4):448-450
[10]湖南制药厂试验室新青霉素合成组《中国医药工业杂志》, 1974(5)。